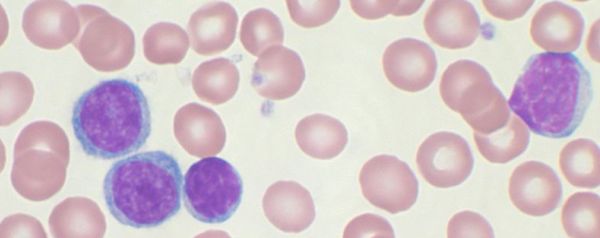

Cellen van ons eigen immuunsysteem lijken, na genetische modificatie, goed in staat te zijn om bloedkanker uit te schakelen.
Het idee om ons eigen immuunsysteem te gebruiken om kanker te bestrijden, is niet nieuw. Onze immuuncellen zijn getraind om op een effectieve manier allerlei ziektes, vreemde stoffen en geïnfecteerde cellen aan te vallen, en kankercellen zouden een welkome toevoeging aan dat lijstje zijn. Maar onderzoek naar deze manier van kankerbestrijding laat vooral zien dat het lastig is om het immuunsysteem in te zetten in de strijd.
Lastig, maar niet onmogelijk, zo zeggen onderzoekers van de University of Pennsylvania in Philadelphia. Zij hebben flinke vooruitgang geboekt bij het inzetten van het immuunsysteem bij het uitschakelen van een bepaalde vorm van bloedkanker (chronische lymfatische leukemie). Bij dit type gaat het om kanker in de zogenoemde B-cellen van het immuunsysteem, die nutteloos worden en ongecontroleerd blijven delen.
De onderzoekers konden deze ziekte een halt toeroepen door andere cellen van het immuunsysteem (T-cellen) te instrueren de B-cellen aan te vallen. Dit deden ze door een aantal T-cellen uit het lichaam te halen, genetisch zo te modificeren dat ze konden binden aan het unieke CD19-eiwit dat zich bevindt op het celoppervlak van alle B-cellen, en weer terug te plaatsen in het lichaam. Daar bleken de new-and-improved T-cellen bij twee van de drie proefpersonen goed in staat de B-cellen, en daarmee de leukemie, uit te schakelen.
Dat maakt deze studie uniek. Andere onderzoeken hebben eerder al geprobeerd T-cellen te gebruiken om B-cellen uit te schakelen, maar slaagden daar altijd maar deels in. Dat kwam voornamelijk doordat de T-cellen zich in het lichaam niet deelden en afstierven voordat ze enig effect konden hebben. Dankzij een extra modificatie zijn de nieuwe T-cellen echter prima in staat om te delen: de ingebrachte T-cellen hadden zich wel duizend keer vermenigvuldigd en waren tot zes maanden na behandeling nog steeds in staat om de B-cellen te bestrijden.
Daar zit ook meteen het grootste struikelblok van deze behandeling. Want hoewel een leven met woekerende B-cellen bepaald geen pretje is, is een leven zonder B-cellen ook niet handig. De cellen vormen namelijk een belangrijk deel van het immuunsysteem. Het lijkt er dus op dat de zoektocht naar de heilige graal – een manier om cellen met kanker te onderscheiden van gezonde cellen – nog voort zal duren. Want dat is en blijft ideaal; dan zijn we in staat de gemodificeerde T-cellen te gebruiken om kanker te bestrijden, terwijl we de gezonde cellen sparen.
Klik hier voor een comic over dit onderzoek.
Bronnen: New England Journal of Medicine, Science Translational Medicine, Nature News, Medical Xpress
Beeld: Mary Ann Thompson/CC BY-SA